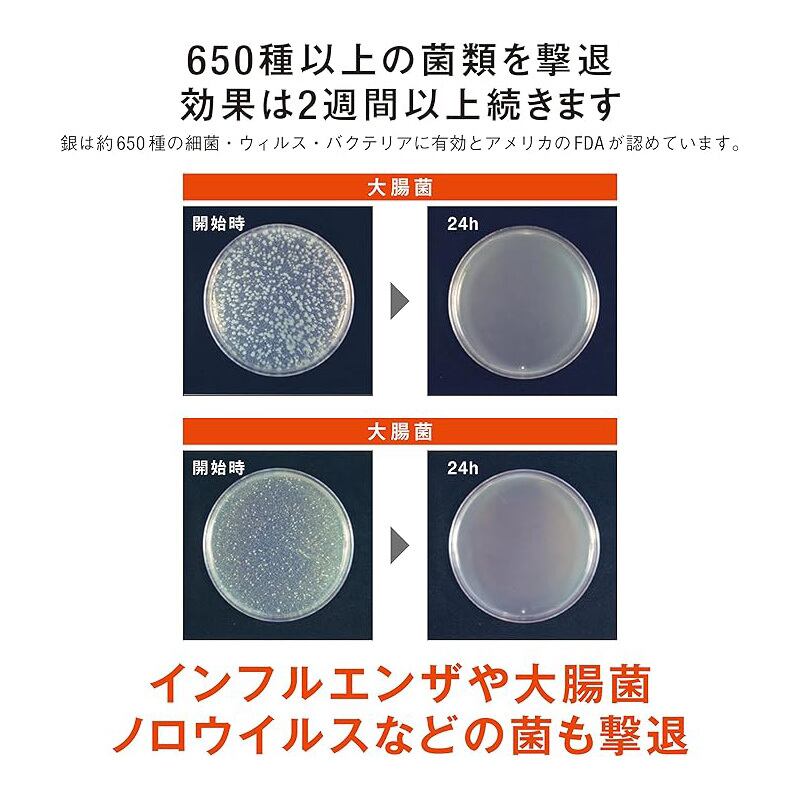

抗菌・防かび dy:gn ディグン 消臭スプレー 100ml 無香料
¥390
International shipping available
ペットや赤ちゃんにも安心のノンアルコール天然素材。
あらゆる素材に使える、拭き取り不要の万能抗菌スプレー。
アルコール以上の除菌力と紫外線に耐性をもち、様々なシーンで気軽に利用可能。
【特徴】
除菌・抗菌・消臭に効果のある銀をナノ化し、ナノシリカと複合化、あらゆる細菌やバクテリア、ウイルス、カビ菌に対する繁殖を制御し従来の抗菌・除菌剤と比較して長期にわたり除菌・抗菌力が持続。
日本の技術が生んだ新素材・特殊無機抗菌剤ナノシルバーシリカネオが実現させた先回り抗菌スプレー。
銀イオンの製造工場であるナノシルバーシリカネオが常にAg+を発生させることで周辺一帯の除菌・抗菌効果が長期間持続。
650種の菌類を撃退する「持ち歩ける周辺一帯・常時抗菌スプレー」で、dy:gnは次のような優位性、独自性、魅力、メリットがあります。
●ノンケミカル&アルコールフリーナノシルバーシリカネオ抗菌スプレー
塗装技術を応用して、ナノサイズの銀イオンの粒子に保湿剤と蒸留水を配合しているので、アルコールや次亜塩素酸などを使いたくない高齢者や乳幼児、肌の弱い方、ペットといっしょのご家庭でも安心。
●一般的なアルコール系、次亜塩素酸系よりも高い除菌・抗菌・消臭効果が長続き
魅力、メリットを理解していただくため、「銀の抗菌性」、「銀の安全性」などの5つの特徴、アルコール系や次亜塩素酸系などおもな除菌剤との比較表、成分マトリクス、消毒・抗菌剤の効果のまとめ、ナノシルバーシリカネオについての説明や効果、メカニズムを掲載しています。
●住まいの除菌・抗菌・消臭だけでなくクルマや外出時、アウトドアにも最適◎
持ち運びやすい100mlのほか、300ml、300mlのエアロゾルタイプをラインナップ。
【用途】
マスク、衣類、社内、トイレ、キッチン用品、介護用品、赤ちゃんのおもちゃなどに
20cm程度離し表面が濡れる程度にスプレーしそのまま乾燥させてください。
お部屋やトイレの消臭はもちろん、毎日欠かせないエアコンもフィルターにスプレーしておけば抗菌・防かびでお部屋を清潔にキープ。
【注意】
・用途以外に使用しないでください
・使用後は立てて保管してください
・飲料用ではごありませんので決して飲まないでください
・肌に合わない方は使用をおやめください
・子供に使用させる場合は保護者監督のもとでご使用ください
・万一飲み込んだ場合は水を飲みすみやかに専門医にご相談ください
・目にはいった場合はすぐに流水で洗い専門医にご相談ください
・幼児の手に届く場所には置かないでください
・直射日光の当たる場所や高温もしくは凍結する場所での保管はお控えください
・食品および食品に触れるものへの塗布、塩素系の消毒薬との併用はお控えください
成分:ナノシルバー、ナノシリカ、保湿成分、精製水
液性:中性
製造元:マイスターズグリッド株式会社
販売元:レモリーノ合同会社
MADE IN JAPAN
抗菌・防かび 【dy:gn ディグン 消臭スプレー 無香料】 ノンアルコール ノンケミカル 天然素材 抗菌スプレー 消臭効果 無添加 無着色 防腐剤フリー 銀イオン